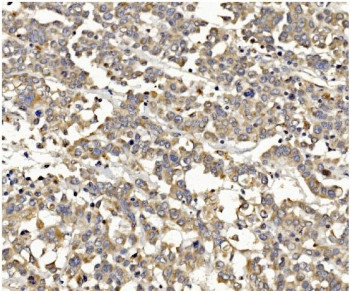

Cookie preferences
This website uses cookies, which are necessary for the technical operation of the website and are always set. Other cookies, which increase the comfort when using this website, are used for direct advertising or to facilitate interaction with other websites and social networks, are only set with your consent.
Configuration
Technically required
These cookies are necessary for the basic functions of the shop.
"Allow all cookies" cookie
"Decline all cookies" cookie
CSRF token
Cookie preferences
Currency change
Customer-specific caching
FACT-Finder tracking
Individual prices
Selected shop
Session
Comfort functions
These cookies are used to make the shopping experience even more appealing, for example for the recognition of the visitor.
Note
Show the facebook fanpage in the right blod sidebar
Statistics & Tracking
Affiliate program
Conversion and usertracking via Google Tag Manager
Track device being used
Item number | Size | Datasheet | Manual | SDS | Delivery time | Quantity | Price |
---|---|---|---|---|---|---|---|
NSJ-RQ5751 | 100 µg | - | - |
3 - 10 business days* |
772.00€
|
If you have any questions, please use our Contact Form.
You can also order by e-mail: info@biomol.com
Larger quantity required? Request bulk
You can also order by e-mail: info@biomol.com
Larger quantity required? Request bulk
0.5mg/ml if reconstituted with 0.2ml sterile DI water. Phosphatidylinositol-4,5-bisphosphate... more
Product information "Anti-PI3K gamma / PIK3CG"
0.5mg/ml if reconstituted with 0.2ml sterile DI water. Phosphatidylinositol-4,5-bisphosphate 3-kinase catalytic subunit gamma isoform is an enzyme that in humans is encoded by the PIK3CG gene. Phosphoinositide 3-kinases (PI3Ks) phosphorylate inositol lipids and are involved in the immune response. The protein encoded by this gene is a class I catalytic subunit of PI3K. Like other class I catalytic subunits (p110-alpha p110-beta, and p110-delta), the encoded protein binds a p85 regulatory subunit to form PI3K. This gene is located in a commonly deleted segment of chromosome 7 previously identified in myeloid leukemias. Several transcript variants encoding the same protein have been found for this gene. Protein function: Phosphoinositide-3-kinase (PI3K) that phosphorylates PtdIns(4,5)P2 (Phosphatidylinositol 4,5-bisphosphate) to generate phosphatidylinositol 3,4,5-trisphosphate (PIP3). PIP3 plays a key role by recruiting PH domain-containing proteins to the membrane, including AKT1 and PDPK1, activating signaling cascades involved in cell growth, survival, proliferation, motility and morphology. Links G-protein coupled receptor activation to PIP3 production. Involved in immune, inflammatory and allergic responses. Modulates leukocyte chemotaxis to inflammatory sites and in response to chemoattractant agents. May control leukocyte polarization and migration by regulating the spatial accumulation of PIP3 and by regulating the organization of F-actin formation and integrin-based adhesion at the leading edge. Controls motility of dendritic cells. Together with PIK3CD is involved in natural killer (NK) cell development and migration towards the sites of inflammation. Participates in T-lymphocyte migration. Regulates T- lymphocyte proliferation and cytokine production. Together with PIK3CD participates in T-lymphocyte development. Required for B-lymphocyte development and signaling. Together with PIK3CD participates in neutrophil respiratory burst. Together with PIK3CD is involved in neutrophil chemotaxis and extravasation. Together with PIK3CB promotes platelet aggregation and thrombosis. Regulates alpha-IIb/beta-3 integrins (ITGA2B/ ITGB3) adhesive function in platelets downstream of P2Y12 through a lipid kinase activity-independent mechanism. May have also a lipid kinase activity-dependent function in platelet aggregation. Involved in endothelial progenitor cell migration. Negative regulator of cardiac contractility. Modulates cardiac contractility by anchoring protein kinase A (PKA) and PDE3B activation, reducing cAMP levels. Regulates cardiac contractility also by promoting beta-adrenergic receptor internalization by binding to GRK2 and by non- muscle tropomyosin phosphorylation. Also has serine/threonine protein kinase activity: both lipid and protein kinase activities are required for beta-adrenergic receptor endocytosis. May also have a scaffolding role in modulating cardiac contractility. Contributes to cardiac hypertrophy under pathological stress. Through simultaneous binding of PDE3B to RAPGEF3 and PIK3R6 is assembled in a signaling complex in which the PI3K gamma complex is activated by RAPGEF3 and which is involved in angiogenesis. [The UniProt Consortium]
Keywords: | Anti-PIK3CG, Anti-p120-PI3K, Anti-PI3Kgamma, Anti-p110gamma, Anti-PI3K-gamma, EC=2.7.11.1, Anti-PI3-kinase subunit gamma, Anti-PtdIns-3-kinase subunit gamma, Anti-PtdIns-3-kinase subunit p110-gamma, Anti-Serine/threonine protein kinase PIK3CG, PI3K gamma |
Supplier: | NSJ Bioreagents |
Supplier-Nr: | RQ5751 |
Properties
Application: | WB, IHC (paraffin), FC, Direct ELISA |
Antibody Type: | Polyclonal |
Conjugate: | No |
Host: | Rabbit |
Species reactivity: | human, mouse, rat |
Immunogen: | Recombinant human protein (amino acids K52-D308) |
Format: | Purified |
Database Information
KEGG ID : | K21289 | Matching products |
UniProt ID : | P48736 | Matching products |
Gene ID : | GeneID 5294 | Matching products |
Handling & Safety
Storage: | +4°C |
Shipping: | +4°C (International: +4°C) |
Caution
Our products are for laboratory research use only: Not for administration to humans!
Our products are for laboratory research use only: Not for administration to humans!
Information about the product reference will follow.
more
You will get a certificate here
Viewed